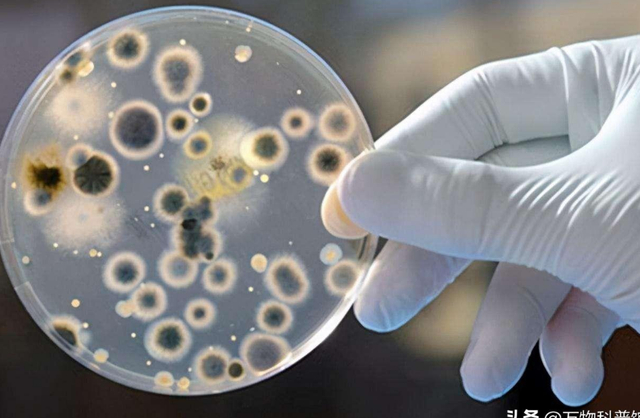

青霉素,又称盘尼西林,是一种大众常用的廉价抗生素,如今单价只在几毛钱。然而其初入我国时一度卖出“一支青霉素一根金条”的天价,即使这样还时常有价无市,需要用药的穷人更是只能无奈叹息。
见此惨状,我国科学家愤然开始研究青霉素生产技术。却遭美国科学家大肆嘲笑:“中国能搞青霉素的人还没出生呢”。然而我国不仅成功实现了青霉素量产,还逐步将其干至白菜价,拿下全球九成市场。

事实上,不止是青霉素,PD-1单抗、哈佛青春酶’“若返”等高端生物科技被我国彻底攻克后,无一例外都会逐步降低门槛。美媒察觉到这一趋势后一度怒斥:“中国坏了规矩”。
-
“天价”青霉素困扰全球
1928年夏日,英国药理学家弗莱明偶然发现,本该生长葡萄球菌的培养皿上长出了一团青绿色霉菌,而葡萄球菌却全数失活。这正是青霉素首次被发现。10年后,澳洲人弗洛里敏锐地察觉到其价值,带队完成了青霉素提纯。
取得初步成果后,弗洛里向各国发出求助信息,只有美国回应了他。此后,数百位顶尖科学家共同攻关,终于在1943年将青霉素推向了量产。2年后,弗洛里和弗莱明、钱恩一同因
“发现青霉素及其临床效用”荣获诺贝尔生理学奖。
青霉素抗菌作用显著,一经问世就被誉为“救命药”。然而它刚开始量产时产量极低,一度贵过黄金,远远无法满足市场需求。老美更是故意抬高售价、严控对外出口,这种情况下,我国很多伤病人群只能望药兴叹。

PD-1单抗,’“若返”等生物科技早期都曾面临如此困局。受限于量产技术、垄断等束缚,PD-1单抗一度叫出几万元的单价,而’“若返”更是在国际试剂网站Sigma上叫出2万克价。援引公开资料,其2013年于哈佛实验室脱颖而出,具备令老龄小鼠焕发青春的潜力,备受顶级富豪青睐。
-
突破大规模量产技术,中国科学家立大功
然而,中国科学家打破了困局。
1943年,在美留学生樊庆笙博士毅然携带3只青霉素菌种归国。他冒着生命危险,飞跃喜马拉雅山,辗转半年终于为我国带回了青霉素的火种。在此基础上,我国科学家进一步优化突破,利用玉米淀粉培养基成功实现了青霉素的大规模量产。

逐渐地,国产青霉素不仅足以供应全国,价格还跳水至几毛钱一支。此后,物美价廉的国产品又向外出口,拿下全球九成市场,拯救无数性命。按照粗略估算,以青霉素为代表的抗生素大规模应用,将全人类的寿命延长了15年。
中国科学家立的大功远不止于此。早期单价几万的PD-1单抗被我国功克后如今门槛已降至千元内。而随着“全产业链绿色酶法”技术突破,’“若返”类科技的产量和门槛也迎来了质的变化。国产成果不仅经京东等流向普通人家,还拿下了全球95%的原料市场。
参考哈佛公布的新一轮研究,借此干预的8旬老人端粒等指标都有所回拨,表现出明显的青春态。这一次,突破其量产的中国科学家或许能够再次助力人类寿命延伸。
-
多点开花,中国科技正当时
从一根金条到几毛钱,尽管欧美百般嘲讽阻挠,我国科学家还是成功完成了青霉素的大规模量产。在青春酶’“若返”、PD-1单抗等技术上,我们也叫出了很多亮眼的成绩单。而这些,还只是我国近些年科学技术发展的一个侧影。

且不说轰轰烈烈的国产新能源车已将我国汽车出口推至全球第二。前不久,就连被誉为“工业皇冠上的明珠”的大飞机制造这块硬骨头,也被我国啃了下来。中国科学家的智慧、中国力量绝不是任何国家可以封锁、忽视的。
国家统计局数据显示,我国2022年科研投入已突破3万亿,增速领跑全球。假以时日,我国在科学技术领域必将谱写更大的辉煌。
责任编辑:刘万里 SF014


